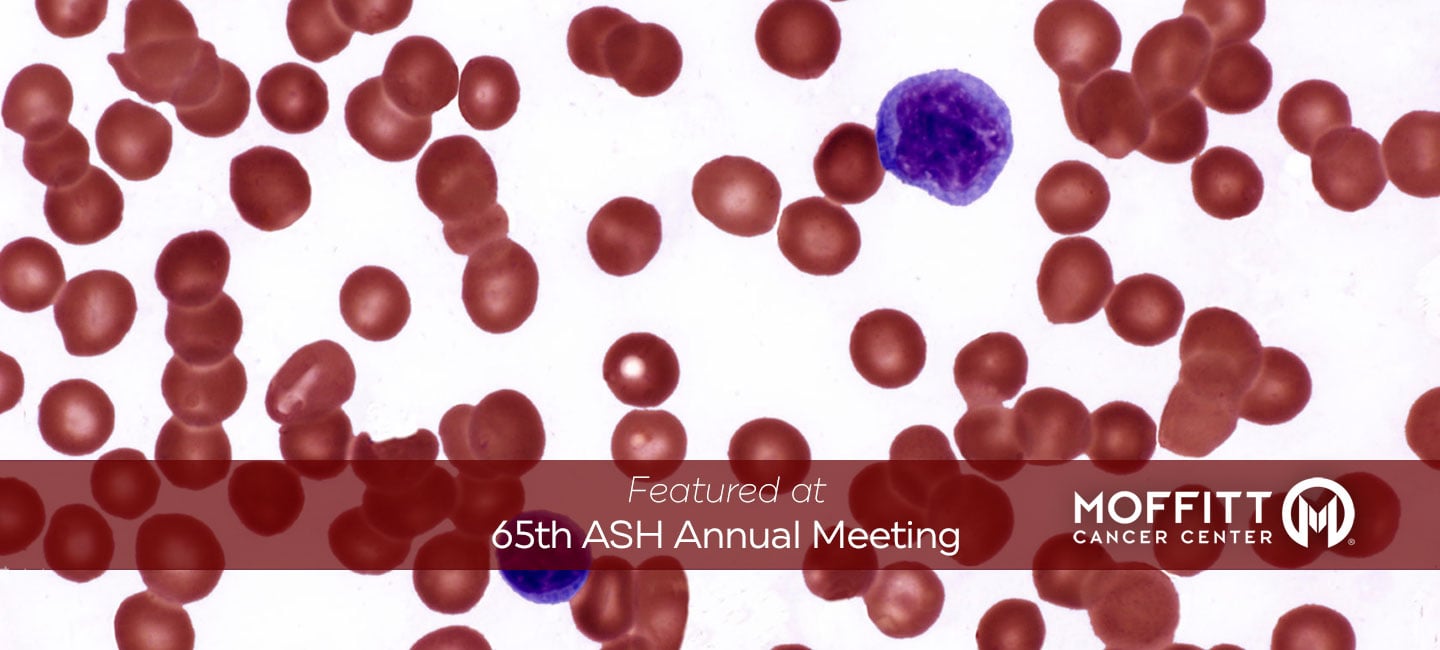

Sara Bondell
Sara Bondell, newsroom manager at Moffitt, got hooked on writing as a kid, filling yellow notepads with stories and observations. This Tampa native attended the University of Tampa and played on the national champion women’s soccer team. After transferring to Emory University, Sara earned degrees in Journalism and English and worked as a broadcast journalist in Georgia and Florida. She remembers useless pop culture trivia and movie quotes, loves all things buffalo chicken and in another life, would be a killer pastry chef. She loves traveling, but Sara’s favorite place is at home with her family and two rescue pups, Penny and Kenai.